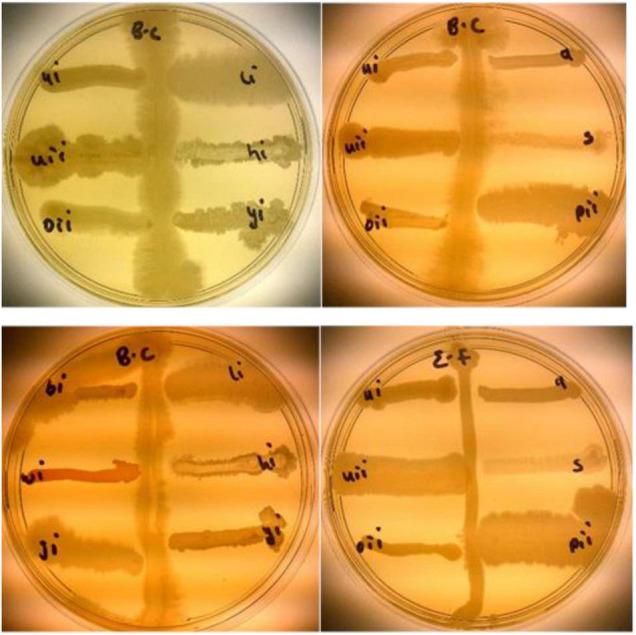
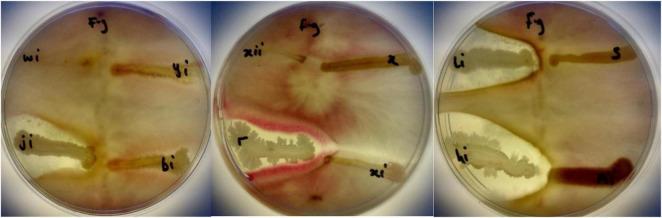

豇豆根际细菌的抗菌和生物肥料潜力。
Bambara Groundnut Rhizobacteria Antimicrobial and Biofertilization Potential.
作者信息
F Ajilogba Caroline, Babalola Olubukola O, Adebola Patrick, Adeleke Rasheed
机构信息
Niche Area for Food Security and Safety, Faculty of Natural and Agricultural Science, North-West University, Mmabatho, South Africa.
Agricultural Research Council-Natural Resources and Engineering, Pretoria, South Africa.
出版信息
Front Plant Sci. 2022 Jul 13;13:854937. doi: 10.3389/fpls.2022.854937. eCollection 2022.
Bambara groundnut, an underutilized crop has been proved to be an indigenous crop in Africa with the potential for food security. The rhizosphere of Bambara groundnut contains Rhizobacteria, with the ability to grow, adapt, and colonize their surroundings even in unfavorable conditions and have not been explored for their plant growth-promoting properties. The aim of this research was to determine the potential of rhizobacteria from Bambara groundnut soil samples as either biofertilizers or biocontrol agents or both to help provide sustainable agriculture in Africa and globally. Bambara groundnut rhizospheric soil samples were collected and analyzed for their chemical composition. Rhizobacteria isolates were cultured from the soil samples. Plant growth-promoting, antifungal activities and phylogenetic analysis using 16S rRNA were carried out on the isolates to identify the rhizobacteria. A 2-year field study planting was carried out to determine the effect of these rhizobacteria as biofertilizers for Bambara groundnut (). The study was carried out in a complete randomized block experimental design with three replications. All the isolates were able to produce ammonia and 1-aminocyclopropane-1-carboxylate, while 4.65, 12.28, and 27.91% produced hydrogen cyanide, indole acetic acid, and solubilized phosphate, respectively, making them important targets as biocontrol and biofertilizer agents. The field results revealed that treatment with rhizobacteria had significant results compared with the control. Characterization of selected isolates reveals their identity as , and sp. These Bacillus isolates have proved to be plant growth-promoting agents that can be used as biofertilizers to enhance the growth of crops and consequent improved yield. This is the first time the rhizobacteria from the Bambara groundnut rhizosphere are applied as biofertilizer.
非洲竹芋,一种未得到充分利用的作物,已被证明是非洲的本土作物,具有保障粮食安全的潜力。非洲竹芋的根际含有根际细菌,即使在不利条件下也有生长、适应和定殖于周围环境的能力,但其促进植物生长的特性尚未得到探索。本研究的目的是确定来自非洲竹芋土壤样本的根际细菌作为生物肥料或生物防治剂或两者兼用的潜力,以帮助在非洲和全球提供可持续农业。采集了非洲竹芋根际土壤样本并分析其化学成分。从土壤样本中培养根际细菌分离株。对分离株进行促进植物生长、抗真菌活性以及使用16S rRNA的系统发育分析,以鉴定根际细菌。进行了为期两年的田间种植研究,以确定这些根际细菌作为非洲竹芋生物肥料的效果()。该研究采用完全随机区组实验设计,重复三次。所有分离株都能够产生氨和1-氨基环丙烷-1-羧酸,而分别有4.65%、12.28%和27.91%的分离株产生氰化氢、吲哚乙酸和溶解磷,这使得它们成为生物防治和生物肥料剂的重要目标。田间结果表明,与对照相比,用根际细菌处理有显著效果。对选定分离株的表征揭示了它们分别为 、 和 属。这些芽孢杆菌分离株已被证明是促进植物生长的剂,可作为生物肥料用于促进作物生长并进而提高产量。这是首次将来自非洲竹芋根际的根际细菌用作生物肥料。